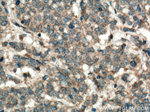
Syntaxin 16 Antibody in Immunohistochemistry (Paraffin) (IHC (P))
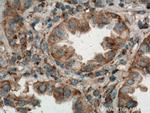
Syntaxin 16 Antibody in Immunohistochemistry (Paraffin) (IHC (P))

Search
Proteintech
Syntaxin 16 Monoclonal Antibody (4A9D8)
{{$productOrderCtrl.translations['antibody.pdp.commerceCard.promotion.promotions']}}
{{$productOrderCtrl.translations['antibody.pdp.commerceCard.promotion.viewpromo']}}
{{$productOrderCtrl.translations['antibody.pdp.commerceCard.promotion.promocode']}}: {{promo.promoCode}} {{promo.promoTitle}} {{promo.promoDescription}}. {{$productOrderCtrl.translations['antibody.pdp.commerceCard.promotion.learnmore']}}

Please note: We are reviewing Western blot images included in the antibody testing data in our catalog, including those provided by third parties. Unless expressly labeled or annotated as “raw-unedited”, Western blot images included in the antibody testing data in our catalog may have been edited, optimized or otherwise adjusted for presentation.
产品信息
66775-1-IG
种属反应
宿主/亚型
分类
类型
克隆号
抗原
偶联物
形式
浓度
规格
纯化类型
保存液
内含物
保存条件
运输条件
产品详细信息
Immunogen sequence: MATRRLTDA FLLLRNNSIQ NRQLLAEQLA DDRMALVSGI SLDPEAAIGV TKRPPPKWVD GVDEIQYDVG RIKQKMKELA SLHDKHLNRP TLDDSSEEEH AIEITTQEIT QLFHRCQRAV QALPSRARAC SEQEGRLLGN VVASLAQALQ ELSTSFRHAQ SGYLKRMKNR EERSQHFFDT SVPLMDDGDD NTLYHRGFTE DQLVLVEQNT LMVEEREREI RQIVQSISDL NEIFRDLGAM IVEQGTVLDR IDYNVEQSCI KTEDGLKQLH KAEQYQKKNR KMLVILILFV IIIVLIVVLV GVKSR (1-321 aa encoded by BC019042)
靶标信息
This gene encodes a protein that is a member of the syntaxin or t-SNARE (target-SNAP receptor) family. These proteins are found on cell membranes and serve as the targets for V-SNARES (vesicle-SNAP receptors) permitting specific synaptic vesicle docking and fusion. A microdeletion in the region of chromosome 20 where this gene is located has been associated with pseudohypoparathyroidism type Ib. Multiple transcript variants encoding different isoforms have been found for this gene.
仅用于科研。不用于诊断过程。未经明确授权不得转售。
篇参考文献 (0)
生物信息学
蛋白别名: MGC90328; RP11-261P9.3; Syntaxin-16
基因别名: 4930401D03; 5430410K23Rik; 6330500A18Rik; AI648908; AW553605; Stx16; Syn16
UniProt ID: (Mouse) Q8BVI5
Entrez Gene ID: (Mouse) 228960, (Rat) 362283




